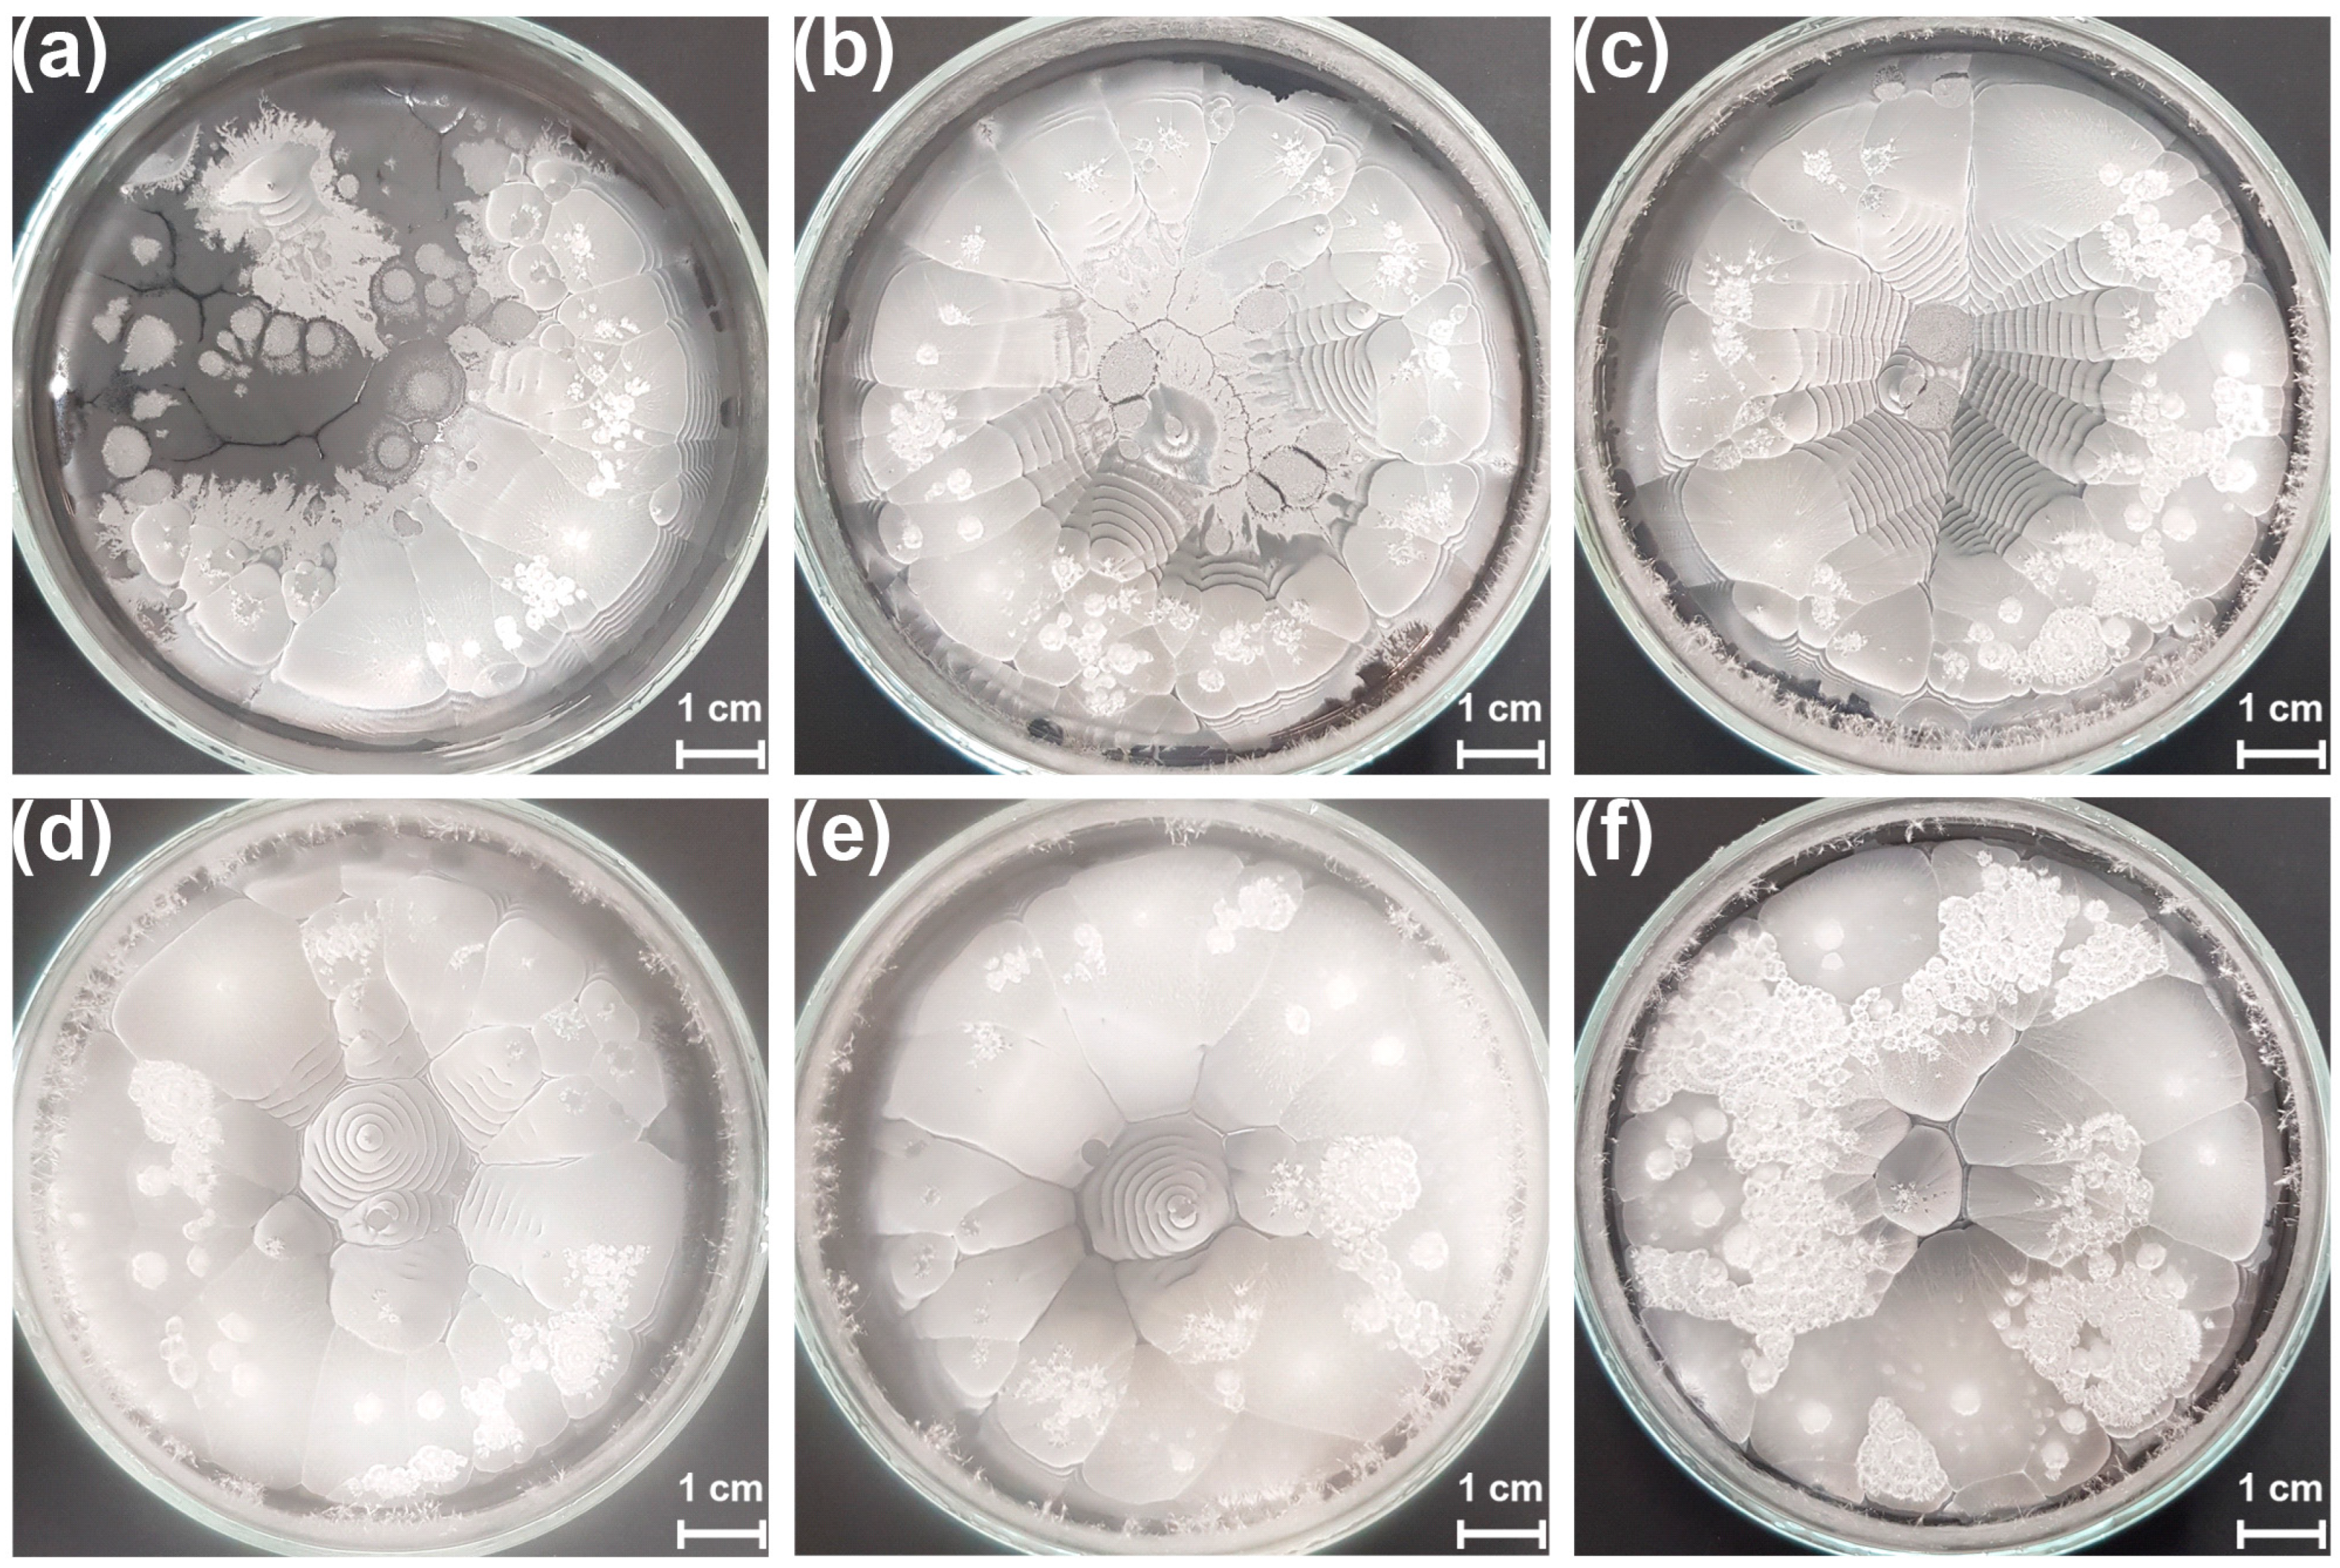
Crystals 15 00017 g001
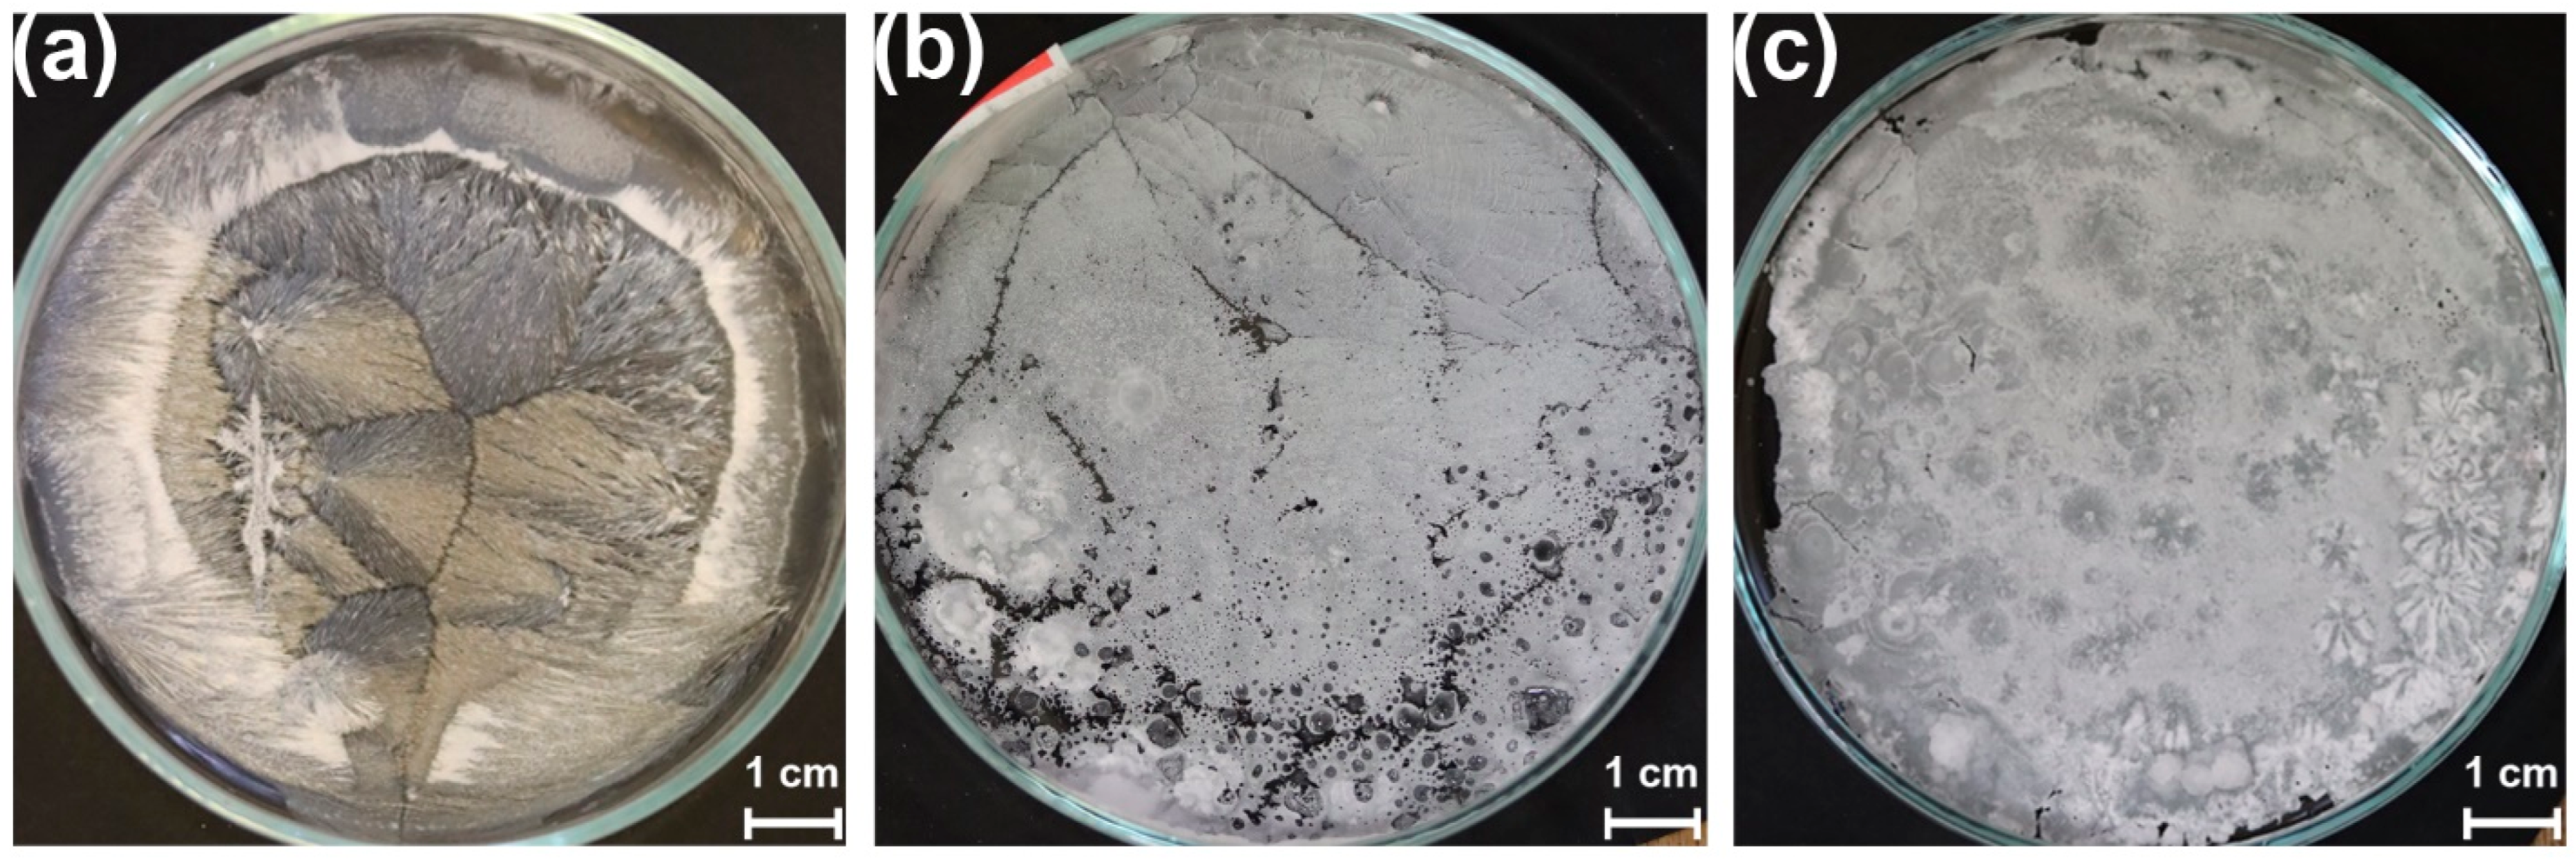
Crystals 15 00017 g008

Abstract
Periodic pattern formation is a prominent phenomenon in chemical, physical, and geochemical systems. This phenomenon can arise from various processes, such as the reaction and mass transport of chemical species, solidification, or solvent evaporation. We investigated the formation of ring-banded spherulites of l-menthol using a thin liquid film in a Petri dish. We found that the film thickness and cooling rate strongly influence the generation of crystallization patterns. We performed two-dimensional numerical simulations using the Cahn–Hilliard model to support the experimentally observed trend on the dependence of the layer thickness on the periodicity of the generated macroscopic patterns. In a specific scenario, we observed the formation of rings consisting of needle-like crystals on the cover of the Petri dish. This phenomenon was due to the evaporation of the menthol and its subsequent crystallization. In addition to these findings, we created crystallization patterns by solvent evaporation (using tert-butyl alcohol, methyl alcohol, and acetone).
1. Introduction
Pattern formation is a fundamental phenomenon observed in nature and various fields of science [1]. These patterns are generated and governed by nonlinear interactions, symmetry breaking, and dynamic instabilities [2,3,4]. In chemical systems, pattern formation arises by the interaction of chemical reactions with mass transport (usually diffusion) [5]. These mechanisms describe how chemical species interact and diffuse to create periodic stationary and spatio-temporal structures, such as the Turing pattern [6,7,8], the Belousov–Zhabotinsky reaction [9], and the periodic precipitation (Liesegang phenomenon) [10,11]. In physical systems, patterns can manifest in fluid dynamics, crystallization, and nonlinear optics [12]. For instance, Rayleigh–Bénard convection cells form due to thermal instabilities [13]. In biological systems, pattern formation arises due to the biochemical and biomechanical processes that self-organize based on genetic and environmental signals [14,15]. Despite their diversity, these systems share common underlying principles, such as direct and delayed feedback loops and mass transport [16]. Studying and understanding pattern formation is essential in fundamental science and fields like materials science and developmental biology [17,18,19]. Ring-banded spherulites are one example of these pattern-formation phenomena occurring in molecular, including polymer, systems [20,21].
Menthol has a chemical formula of C10H20O, making it a heavy molecule with a molar mass of 156 g mol−1. The natural occurrence of menthol is the (1R,2S,5R) configuration (l- or (−)-menthol), which was first isolated in 1771 [22]. It is widely used in the food industry as a food flavoring and in the cosmetic and pharmaceutical industries. Menthol triggers the temperature-sensitive TRPM8 (transient receptor potential melastatin 8) ion channel receptors responsible for the cooling sensation [23]. Menthol also has an essential neurological role because it can block the voltage-gated sodium ion channels in the neurons’ cell membrane and, consequently, reduces neural activity [24]. Furthermore, menthol is a GABA receptor-positive allosteric modulator [25], and by modulating the GABA receptor, it has similar anesthetic properties to propofol [26]. Due to its effective antibacterial properties on lactobacilli and streptococci, menthol has already been used in dental care as an antibacterial agent [27]. Various groups have recently reported the anticancer properties of monoterpenes. Limonene and geraniol have induced apoptosis in specific cancer cells [28]. Experimental and in silico procedures were combined to investigate the effect of l-menthol treatment of human adenocarcinoma CaCo-2 cell lines on gene expression modulation [29]. The authors showed that l-menthol treatment induced noticeable apoptosis in the cancer cells.
In general, crystallization requires a perturbation of the cooling system to initiate the nucleation process. This perturbation could happen via a solid phase body (heterogeneous nucleation) or other perturbations that initiate homogeneous nucleation. The periodic pattern formation of sulfur [30], menthol [31], and acetanilide [32] was reported long ago, and the phenomena were explained by the existing temperature differences between the liquid–gas and liquid–solid substrate interfaces [33]. Benbow and Wood [34] concluded that significant supercooling and strong surface tension temperature dependence are required to form ring-banded spherulites. Yuasa et al. [31] observed whisker growth during the crystallization of l-menthol. The same authors noticed that whisker growth significantly affects medicine stability and mechanical strength [35]. Some authors raised the question of whether macroscopic chiral morphologies are related to molecular chiral configuration, but this is still generally unanswered [36,37].
Self-organization also plays a crucial role in designing and engineering periodic structures on the surfaces in many wet lithographic applications at the microscale [38]. Several phenomena, such as self-assembly, crystallization, dewetting, and phase separation, determine the chemical and physical properties of the generated structures, and thus their potential usage in technological applications [39,40,41,42,43]. For instance, optimizing crystallization can significantly improve the efficiency of organic electronic devices [44].
Crystallization is a process in which chemical entities (atoms, ions, molecules, nanoparticles) self-assemble into regular (crystal) structures, forming solids. The crystal structure is a repetition of a unit cell, which is the smallest repeating unit. The periodicity of these units is at the nanometer scale. However, periodic structures (for example, ring-banded spherulites) can arise at the macroscale when crystallization meets other phenomena, such as diffusion and interfacial-related flows [36]. In this case, the wavelength of these structures may range from micrometer to centimeter scales.
In our previous paper, we investigated the crystallization of two enantiomeric (l- and d-) and racemic menthol thin films in glass vials [45]. Pure menthol enantiomers (either l- or d-) and mixtures up to a mixing ratio of 0.15 formed ring-banded spherulites that did not show any macroscopic chirality; however, the mixtures of enantiomers above a mixing ratio of 0.20 formed only non-banded spherulites. In this study, the thickness of the formed liquid layer on the vertically oriented vial surface could not be controlled.
In this study, we investigated the crystallization of l-menthol liquid film in a Petri dish and the effect of liquid layer thickness on the macroscopic appearance of the crystallization pattern. We found an optimal layer thickness at which the dominant pattern is the ring-banded spherulites. We also examined the effect of the cooling rate on the pattern formation. We identified that the medium cooling rate (at room temperature) provided the best condition for forming ring-banded spherulites. To support the dependence of the layer thickness on the wavelength of the macroscopic pattern, we performed two-dimensional numerical simulations using a spinodal decomposition scenario. Finally, we investigated the formation of crystallization patterns by utilizing organic solvent evaporation.
2. Materials and Methods
2.1. Formation of Ring-Banded Spherulites Using Pure Menthol
The crystallization of l-menthol (Sigma-Aldrich, Burlington, MA, USA) was initially tested in borosilicate test tubes, glass microscope slides, polystyrene (plastic), and borosilicate (glass) Petri dishes. We observed no significant difference in the basic crystallization pattern using different materials and geometries. Therefore, the detailed investigation was carried out in glass Petri dishes with a diameter of 8.5 cm and a height of 1.1 cm. In the typical experiments, various amounts of l-menthol were placed in the Petri dish and covered to avoid evaporation of the sample. The sample was heated using a block heater (VWR) until it was completely melted and formed a uniform liquid layer (the temperature of the block heater surface was set to (50 ± 0.1) °C. The samples were cooled at three cooling rates. Slow cooling was achieved by letting the sample cool at the heating surface after switching off the power, medium cooling was realized by cooling at room temperature ((22 ± 0.5) °C), and rapid cooling was achieved by putting the Petri dish into the ice/water bath. After the solidification of the samples, the crystallization patterns were monitored by an image-processing system using a camera (Canon 90D, Canon, Tokyo, Japan) with a macro-objective (Canon EF-S 60 mm f/2.8 macro USM lens, Canon, Tokyo, Japan). The crystal structures of the ring-banded spherulites and crystals formed in the cover glass of the Petri dish were investigated using optical microscopes (VWR Compound Laboratory Microscope, VWR International, Radnor, PA, USA and Celestron 44345, Celestron, Torrance, CA, USA). The needle-like crystals of the ring-banded spherulites were investigated using the VWR Compound Laboratory Microscope by removing a tiny amount of crystals from the solidified layer using a metal spatula (with a flat end). Then, these was placed on a microscope slide and covered with a cover glass.
2.2. Crystallization of Menthol in Confined Space
In a typical experiment, the two glass microscope slides (VWR) were preheated to (50 ± 0.1) °C using a block heater surface. Then, the liquid l-menthol ((50 ± 0.1) °C) was added to the surface of the slide, which was then covered by another microscope slide with 0.3 mm spacers between them. The liquid menthol could freely flow from the gap between the two slides. The crystallization pattern formation was investigated at room temperature and monitored as described in the previous section.
2.3. Crystallization of Menthol Using Organic Solvents
The crystallization of l-menthol generated by solvent evaporation was carried out in glass Petri dishes with a diameter of 8.5 cm and a height of 1.1 cm. In a typical experiment, 1.6 g menthol was dissolved in 4 mL of various organic solvents such as tert-butyl alcohol (Sigma-Aldrich), methyl alcohol (Sigma-Aldrich), and acetone (Sigma-Aldrich). This solution was transferred to the Petri dish, and the crystallization structures appeared due to the solvent evaporation. All experiments were conducted at room temperature ((22 ± 0.5) °C).
3. Results
3.1. Effect of the Liquid Layer Thickness
In the first set of experiments, we investigated the effect of the thickness of the liquid menthol layer on the macroscopic appearance of the crystallization pattern. Figure 1 shows the stationary patterns after the solidification (~10 min) by applying a medium cooling rate (e.g., the samples were cooled at room temperature). At a low amount of menthol (0.60 g), periodic pattern formation occurred only at the edge of the Petri dish (Figure 1a). Under 0.60 g, we did not observe a continuous liquid layer formation in the Petri dish. When the menthol amount was increased, ring-banded spherulites also formed in the center part of the Petri dish (Figure 1b). The optimal amount of the menthol was 1.20 g (this corresponds to a 0.30 mm thick liquid layer considering the radius of the Petri dish and menthol density of 0.709 g cm−3); in this case, the largest domain of the periodic pattern formation was obtained (Figure 1c). Once the amount of menthol increased, the domain size of the periodic pattern decreased, and the thickness of the solidified layer increased with the formation of additional crystals on top of the menthol crystal layer (Figure 1d–f). Most dominantly, the crystallization started from the edge of the Petri dish, advancing to the central part of the container. Transmission optical microscopy investigation revealed that the ring-banded spherulites comprised repeating low- and high-packed regions of needle-like menthol crystals (Figures S1 and S2). The thickness of those crystals was a few micrometers (Figure S3). The former finding opposes the results obtained in our previous study, in which the formation of the ring-banded spherulites was investigated and generated from a thin liquid film of l-menthol on glass vial surfaces. In this case, the ring-banded spherulites consisted of crystal-free and high-packed crystal regions [45].
Figure 1.
Formation of crystallization patterns from a thin liquid film of l-menthol in a Petri dish using various amounts of menthol, (a) m = 0.60 g, (b) m = 0.80 g, (c) m = 1.20 g, (d) m = 1.60 g, (e) m = 2.00 g, and (f) m = 3.00 g. The crystallization occurred at room temperature ((22 ± 0.5) °C).
We also examined the effect of the amount of menthol used on the wavelength of the periodic pattern. We found two regimes of the behavior (Figure 2). At a low amount of menthol, the periodicity dramatically decreased (regime I), approaching a minimum value for the wavelength of the pattern (~1.1 mm). After this point, the wavelength increased with the amount of menthol (regime II). To support qualitatively the experimental results, we used the Cahn–Hilliard (CH) equation [46], which is an effective model to describe phase separation and other related pattern formation phenomena in complex chemical systems with mass transport (e.g., diffusion, advection) [47,48,49]. This equation requires knowledge of the free energy of the system. In the case of homogeneous systems, the free energy must have two minima, corresponding to the low- and high-density phases. When the local density (concentration) of the material reaches a threshold (called spinodal point), the system starts to segregate into high- and low-density states. In our systems, the high- and low-density phases correspond to regions with high- and low-crystal-density regions. CH equation in two dimensions has the following form:
where c is the concentration (amount or density) of a chemical compound; λ is the kinetic constant determining the characteristic timescale of the phase separation corresponding to the diffusion of the compound in the system; σ is a thermodynamic parameter of the model, namely, the surface tension; and ∇ is the Nabla operator. It should be noted that the CH model is thermodynamic and contains only the thermodynamic parameters of the system. This approach uses no (chemical) kinetic parameters.
Figure 2.
Effect of the amount of menthol (layer thickness) on the periodicity (wavelength) of the produced periodic pattern formed in the Petri dish. The crystallization occurred at room temperature (22 ± 0.5 °C). In the experiments, two regimes were identified with decreasing (regime I) and increasing (regime II) trends.
The CH equation (Equation (1)) was solved numerically using the method of lines on a rectangular 2D computational domain, which used equidistant grid spacing in both directions (Δx = Δz = 1.0). The time integration was performed using a backward Euler method with the dimensionless time step of 0.01. The following parameters of the CH equation were used: λ = 1.0 and σ = 1.0. All variables and parameters in the model are dimensionless. The initial condition of c was 0.3 at all grid points. It should be noted that the initial concentration of menthol in the simulations was above the spinodal point (threshold concentration), resulting in that the system was in a metastable state. However, no phase separation occurred because of the homogeneous spatial distribution of the concentration—the concentration reached the spinodal point in all grid points. Therefore, a perturbation must be applied to initiate a planar solidification front. Thus, we increased the value of c to 1.0 at the beginning of the simulations on the left side of the computational domain in the following form: c(t = 0, [0 < x < 20], [0 < z < zmax]) = 1.0. In the simulations, the size of the computational domain was xmax × zmax, where xmax was 500, while zmax varied in the range of 5 and 30. A no-flux boundary condition was applied at all boundaries of the computational domain.
Figure 3 shows the results of the numerical simulations varying the thickness of the liquid layer. The model could reproduce two essential features of the experimental system: the formation of the macroscopic periodic pattern and the variation in the wavelength of the pattern with the thickness of the layer. As one can see, the wavelength of the macroscopic pattern increased with the thickness of the layer. This result is in good accordance with the trend observed in experiments in regime II (Figure 4). It should be noted that the model cannot reproduce the opposite trend corresponding to regime I. To understand this switch, further investigation into the rhythmic crystallization of menthol is needed. Interestingly, in the case of the thick layer, we obtained a zig-zag structure in the simulations (Figure 3c), and similar behavior was found in a precipitation system (silver dichromate) [50]. It was observed that the generation of zig-zag patterns in experiments required a minimum thickness of the reactive layer.
Figure 3.
Effect of the thickness of the layer on the wavelength of the crystallization pattern in numerical simulations, (a) z = 5, (b) z = 10, and (c) z = 15. The planar solidification front traveled from left to right. The graphs are not to scale. Red and blue domains correspond to high and low crystal densities.
Figure 4.
Dependence of the amount of menthol/layer thickness on the periodicity of the produced periodic pattern formed in (a) the experiments (regime II) and (b) the numerical simulations.
It should be mentioned, however, that the CH model reproduced the main feature of the phenomenon, namely, the periodic structure formation. We hypothesize that the formation of ring-banded spherulites is not only driven solely by diffusion and crystallization of menthol (captured in the CH model), but other phenomena can play significant roles. The periodic structure formation can also be affected by the coffee-ring effect originating from the evaporation-induced capillary flow [51,52]. The crystal growth starts at a random nucleation center. Crystallization induces the diffusion of the menthol molecules from the liquid regions toward the solid material, depleting them in the vicinity of the crystal. However, the capillary flow can also significantly contribute to the spatial distribution of menthol molecules in the liquid film. A new nucleation event occurs farther from the formed crystal when the local amount of menthol reaches the nucleation threshold again. We crystallized the liquid menthol in the confined liquid phase (between two glass microscope slides using a 0.3 mm spacer) to highlight the importance of the interfacial tension-related phenomenon in the periodic pattern formation. In this case, we observed only the formation of a spherulite (Figure S4).
3.2. Effect of Cooling Rate
Next, we investigated the effect of the cooling rate on the pattern formation. We deployed three cooling rates using the same amount of menthol (1.20 g, Figure 5a). When slow cooling was applied, instead of periodic pattern formation, we observed a needle-like crystal formation with several domains where the growing domains were separated (Figure 5b). As discussed earlier, we obtained periodic patterns at the medium cooling rate (i.e., cooling at room temperature) (Figure 5c). However, when rapid cooling was introduced, many crystals were produced due to the high extent of supercooling (Figure 5d). In this case, the thin liquid layer reached the freezing point of menthol within several seconds. It took less than a minute and 16 min during medium and slow cooling, respectively.
Figure 5.
(a) The temperature courses using slow (black solid line), medium (red solid line), and fast (blue solid line) cooling. Solidification patterns generated by applying various cooling rates: (b) slow, (c) medium, and (d) fast. The thin gray line indicates the melting point interval ((41.2–41.7) °C).
We observed an interesting phenomenon when the amount of menthol ranged from 0.35 g to 0.70 g. During this range, we noted the formation of rings on the cover of the Petri dish as a result of menthol evaporation. Initially, tiny droplets appeared on the cover. Over time, these droplets solidified into rings composed of thin, needle-like menthol crystals (Figure 6). Upon closer inspection, we found that most rings were physically connected by at least one crystal needle. We repeated the experiment on a plastic surface while keeping all other parameters the same and confirmed that the substrate material did not affect the observed phenomenon. Below 0.35 g of menthol, we did not observe any droplet formation on the cover due to the insufficient amount of menthol. Instead, only a thin layer formed on the cover without any droplets. When the menthol amount exceeded 0.70 g, the evaporation rate in the Petri dish intensified, resulting in a continuous layer forming on the surface. This layer also solidified without the formation of droplets.
Figure 6.
Formation of menthol rings on the cover glass of the Petri dish using 0.50 g menthol and the medium cooling rate. (a,b) Optical photographs of the covers, and (c) optical micrograph showing the fine structure of the rings.
The size dispersity of the rings was high because of the formation of a few big and numerous small crystal rings (Figure 6b). However, the average diameters of solid menthol rings showed an increasing trend with total menthol mass, which can be explained by the fact that the more intense evaporation may generate bigger droplets on the cover of the Petri dish (Figure 7).
Figure 7.
Variation in the average diameter of crystal rings as a function of the mass of l-menthol.
3.3. Effect of Solvent Evaporation
In one-component systems, rhythmic crystallization occurs due to the solidification. However, another strategy known to create such a structure is the evaporation of the solvent. One of the emblematic examples of it is the pattern formation in the ascorbic acid/methanol system generating ring-banded spherulites. The phenomenon is driven by evaporation, interfacial tension, and crystallization [53]. Following this approach, we investigated the crystallization pattern formation driven by organic solvent evaporation using tert-butyl alcohol, methyl alcohol, and acetone. Figure 8 presents the results, showing that solvent evaporation did not generate periodic patterns of menthol from a thin liquid film. In the case of tert-butyl alcohol, the pattern consisted of needle-like crystals (Figure 8a). However, in the case of methyl alcohol and acetone, we obtained a non-homogeneous layer formation with some features on its surface (Figure 8b,c). The difference in the evaporation rate of the solvents can explain these results. Among these three solvents, tert-butyl alcohol has the highest boiling point (83.0 °C). Methanol and acetone have a boiling point of 64.7 °C and 56.3 °C, respectively. Therefore, the slowest evaporation occurred in the case of tert-butyl alcohol, providing enough time to form needle-like crystals. In the other two cases, the faster evaporation generated a solid amorphous layer of menthol.
Figure 8.
Crystallization pattern of menthol generated by the evaporation of organic solvents: (a) tert-butyl alcohol, (b) methyl alcohol, and (c) acetone.
4. Conclusions
In this work, we investigated the effect of the liquid film thickness and cooling rate on the crystallization pattern formation of l-menthol in a Petri dish. We found that at the film thickness of ~0.30 mm, the dominant pattern in the Petri dish was ring-banded spherulites. The cooling rate of the samples also played a crucial role in the pattern formation. A slow cooling rate generated the formation of domains of the needle-like crystals. Fast cooling produced numerous small crystals. However, the medium cooling rate provided periodic pattern. Interestingly, at the low amount of menthol, we observed the formation of crystal rings on the cover of the Petri dish consisting of tiny needle-like crystals. The average size of these rings correlated with the amount of menthol used. The model simulation using the CH equation could support the experimentally observed trend on the variation in the wavelength of the macroscopic pattern with the menthol layer thickness. Finally, we investigated the pattern formation utilizing solvent evaporation using several organic solvents. This pattern generation strategy did not provide any periodic patterns. However, slow and fast solvent evaporation provided needle-like crystals and homogeneous solid layer formation in the Petri dish. This knowledge gathered in this investigation can be used in other chemical systems to control the crystallization of l-menthol. A recent study investigated the phase separation and crystallization of l-menthol and biologically active chitosan l- and d-aspartate nanoparticles in a two-phase system (water and ethanol) [54]. They found that crystalline phase separation involved l-menthol crystallization into optically anisotropic fibrillar particles. These findings can contribute to the design of fundamental principles of phase separation in intracellular communication and regulation.
Supplementary Materials
The following supporting information can be downloaded at: https://www.mdpi.com/article/10.3390/cryst15010017/s1. Figure S1: Structure of the crystallization center of the ring-banded spherulite formed in a Petri dish using 1.20 g of l-menthol. The crystallization occurred at room temperature ((22 ± 0.5) °C); Figure S2: Structure of the ring-banded spherulite in a Petri dish using 1.20 g of l-menthol. The crystallization occurred at room temperature ((22 ± 0.5) °C); Figure S3: Optical micrograph of the needle-like menthol crystals collected from the ring-banded spherulite in a Petri dish using 1.20 g of l-menthol. The crystallization occurred at room temperature ((22 ± 0.5) °C); Figure S4: Formation of a spherulite of the l-menthol in the confined liquid phase (between two glass microscope slides using a 0.3 mm spacer).
Author Contributions
Conceptualization, T.K. and I.L.; methodology, T.K. and I.L.; validation, T.K., M.D., F.G., M.I. and I.L.; formal analysis, M.I.; investigation, T.K.J., M.D. and F.G.; writing—original draft preparation, T.K. and I.L.; writing—review and editing, T.K. and I.L.; supervision, I.L.; project administration, I.L.; funding acquisition, I.L. All authors have read and agreed to the published version of the manuscript.
Funding
This research was funded by the JSPS Postdoctoral Fellowship Program for Overseas Researchers (identification number 202260298); the HUN-REN Hungarian Research Network; the National Research, Development and Innovation Office of Hungary (K146071); and the Ministry of Culture and Innovation and the National Research, Development and Innovation Office under grant nr. TKP2021-EGA-02.
Data Availability Statement
The datasets generated during and/or analyzed during the current study are available from the corresponding author upon reasonable request.
Conflicts of Interest
The authors declare no conflicts of interest.
References
- Nicolis, G.; Prigogine, I. Self-Organization in Nonequilibrium Systems; Wiley-Interscience: New York, NY, USA, 1977. [Google Scholar]
- Cross, M.C.; Hohenberg, P.C. Pattern formation outside of equilibrium. Rev. Mod. Phys. 1993, 65, 851–1112. [Google Scholar] [CrossRef]
- Epstein, I.R.; Showalter, K. Nonlinear chemical dynamics: Oscillations, patterns, and chaos. J. Phys. Chem. 1996, 100, 13132–13147. [Google Scholar] [CrossRef]
- Gray, P.; Scott, S.K. Chemical Oscillations and Instabilities: Non-Linear Chemical Kinetics; Oxford Academic: Oxford, UK, 1990. [Google Scholar]
- Vanag, K.V.; Epstein, I.R. Cross-diffusion and pattern formation in reaction–diffusion systems. Phys. Chem. Chem. Phys. 2009, 11, 897–912. [Google Scholar] [CrossRef]
- Castets, V.; Dulos, E.; Boissonade, J.; De Kepper, P. Experimental evidence of a sustained standing Turing-type nonequilibrium chemical pattern. Phys. Rev. Lett. 1990, 64, 2953–2956. [Google Scholar] [CrossRef] [PubMed]
- Horváth, J.; Szalai, I.; De Kepper, P. An experimental design method leading to chemical Turing patterns. Science 2009, 324, 772–775. [Google Scholar] [CrossRef]
- Ali, I.; Saleem, M.T. Spatiotemporal dynamics of reaction–diffusion system and its application to Turing pattern formation in a Gray–Scott model. Mathematics 2023, 11, 1459. [Google Scholar] [CrossRef]
- Zaikin, A.N.; Zhabotinsky, A.M. Concentration wave propagation in two-dimensional liquid-phase self-oscillating system. Nature 1970, 225, 535–537. [Google Scholar] [CrossRef] [PubMed]
- Nabika, N.; Itatani, I.; Lagzi, I. Pattern formation in precipitation reactions: The Liesegang phenomenon. Langmuir 2020, 36, 481–497. [Google Scholar] [CrossRef] [PubMed]
- Nakouzi, E.; Steinbock, O. Self-organization in precipitation reactions far from the equilibrium. Sci. Adv. 2016, 2, e1601144. [Google Scholar] [CrossRef] [PubMed]
- Bodenschatz, E.; Imbihl, R.; Rehberg, I. Focus on pattern formation. New J. Phys. 2003, 5, 003. [Google Scholar] [CrossRef]
- Manneville, P. Rayleigh-Bénard convection: Thirty years of experimental, theoretical, and modeling work. In Dynamics of Spatio-Temporal Cellular Structures; Mutabazi, I., Wesfreid, J.E., Guyon, E., Eds.; Springer: New York, NY, USA, 2006; Volume 207, pp. 41–65. [Google Scholar]
- Schweisguth, F.; Corson, F. Self-organization in pattern formation. Dev. Cell 2019, 49, 659–677. [Google Scholar] [CrossRef]
- Landge, A.N.; Jordan, B.M.; Diego, X.; Müller, P. Pattern formation mechanisms of self-organizing reaction-diffusion systems. Dev. Biol. 2020, 460, 2–11. [Google Scholar] [CrossRef] [PubMed]
- Blanchini, F.; Samaniego, C.C.; Franco, E.; Giordano, G. Homogeneous time constants promote oscillations in negative feedback loops. ACS Synth. Biol. 2018, 7, 1481–1487. [Google Scholar] [CrossRef] [PubMed]
- Saliba, D.; Ammar, M.; Rammal, M.; Al-Ghoul, M.; Hmadeh, M. Crystal growth of ZIF-8, ZIF-67, and their mixed-metal derivatives. J. Am. Chem. Soc. 2018, 140, 1812–1823. [Google Scholar] [CrossRef] [PubMed]
- Farkas, S.; Holló, G.; Schuszter, G.; Deák, Á.; Janovák, L.; Hornok, V.; Itatani, M.; Nabika, H.; Horváth, D.; Tóth, Á.; et al. Reaction–diffusion assisted synthesis of gold nanoparticles: Route from the spherical nano-sized particles to micrometer-sized plates. J. Phys. Chem. C 2021, 125, 26116–26124. [Google Scholar] [CrossRef]
- Kondo, S. The present and future of Turing models in developmental biology. Development 2022, 149, dev200974. [Google Scholar] [CrossRef] [PubMed]
- Shtukenberg, A.G.; Punin, Y.O.; Gunn, E.; Kahr, B. Spherulites. Chem. Rev. 2012, 112, 1805–1838. [Google Scholar] [CrossRef] [PubMed]
- Lovinger, A.J. Twisted crystals and the origin of banding in spherulites of semicrystalline polymers. Macromolecules 2020, 53, 741–745. [Google Scholar] [CrossRef]
- Gaubius, H.D. Adversoriorum Varii Argumenti I; Apud et Luchtmans: Leiden, The Netherlands, 1771. [Google Scholar]
- Eccles, E. Menthol and related cooling compounds. J. Pharm. Pharmacol. 1994, 46, 618–630. [Google Scholar] [CrossRef]
- Haeseler, G.; Mause, D.; Grosskreutz, J.; Bufler, J.; Nentwig, B.; Piepenbrock, S.; Dengler, R.; Leuwer, M. Voltage-dependent block of neuronal and skeletal muscle sodium channels by thymol and menthol. Eur. J. Anaesthes. 2002, 19, 571–579. [Google Scholar] [CrossRef]
- Lau, B.K.; Goodchild, A.K.; Drew, G.M.; Karim, S.; Vaughan, C.V. Menthol enhances phasic and tonic GABAA receptor-mediated currents in midbrain periaqueductal grey neurons. Br. J. Pharmacol. 2014, 171, 2803–2813. [Google Scholar] [CrossRef]
- Watt, E.E.; Betts, B.A.; Kotey, F.O.; Humbert, D.J.; Griffith, T.N.; Kelly, E.W.; Veneskey, K.C.; Gill, N.; Rowan, K.C.; Jenkins, A.; et al. Menthol shares general anesthetic activity and sites of action on the GABA(A) receptor with the intravenous agent, propofol. Eur. J. Pharmacol. 2008, 590, 120–126. [Google Scholar] [CrossRef]
- Freires, I.A.; Denny, C.; Benso, B.; de Alencar, S.M.; Rosalen, P.L. Antibacterial activity of essential oils and their isolated constituents against cariogenic bacteria: A systematic review. Molecules 2015, 20, 7329–7358. [Google Scholar] [CrossRef]
- Loza-Tavera, H. Monoterpenes in essential oils. In Chemicals via Higher Plant Bioengineering; Shahidi, F., Kolodziejczyk, P., Whitaker, J.R., Munguia, A.L., Fuller, G., Eds.; Springer Science + Business Media: New York, NY, USA, 1999; pp. 49–62. [Google Scholar]
- Faridi, U.; Dhawan, S.S.; Pal, S.; Gupta, S.; Shukla, A.K.; Darokar, M.P.; Sharma, A.; Shasany, A.K. Repurposing L-menthol for systems medicine and cancer therapeutics? L-Menthol induces apoptosis through Caspase 10 and by suppressing HSP90. Omics A J. Integr. Biol. 2016, 20, 53–64. [Google Scholar] [CrossRef] [PubMed]
- Fischer-Treuenfeld, A. Rhytmic formations in the solidification of sulfur. Kolloid-Z. 1915, 16, 109–111. [Google Scholar] [CrossRef]
- Yuasa, H.; Ooi, M.; Takashima, Y.; Kanaya, Y. Whisker growth of L-menthol in coexistence with various excipients. Int. J. Pharm. 2000, 203, 203–210. [Google Scholar] [CrossRef] [PubMed]
- Hedges, E.S. Periodic and spiral forms of crystallization. Nature 1929, 123, 837–838. [Google Scholar] [CrossRef]
- Garner, W.E.; Randall, F.C. Alternation in the heats of crystallisation of the normal monobasic fatty acids. Part I. J. Chem. Soc. 1924, 125, 881–896. [Google Scholar] [CrossRef]
- Benbow, J.J.; Wood, D.J.C. Unusual liquid-solid transition effects in a methoxypentamethylflavan. Proc. R. Soc. Lond. Ser. Math. Phys. Sci. 1958, 243, 518–533. [Google Scholar]
- Yuasa, H.; Kanaya, Y.; Asahina, K. Studies on whisker growth on the tablet surface. III.: Mechanism of whisker growth on aspirin tablet and its effect on the mechanical strength of the tablet. Chem. Pharm. Bull. 1986, 34, 850–857. [Google Scholar] [CrossRef] [PubMed]
- Shtukenberg, A.G.; Cui, X.; Freudenthal, J.; Gunn, E.; Camp, E.; Kahr, B. Twisted mannitol crystals establish homologous growth mechanisms for high-polymer and small-molecule ring-banded spherulites. J. Am. Chem. Soc. 2012, 134, 6354–6364. [Google Scholar] [CrossRef] [PubMed]
- Bernauer, F. “Gedrillte” Kristalle: Verbreitung, Entstehungsweise und Beziehungen zu Optischer Aktivität und Molekülsymmetrie; Gebrüder Borntraeger: Berlin, Germany, 1929. [Google Scholar]
- Paul, D.; Saias, L.; Pedinotti, J.-C.; Chabert, M.; Magnifico, S.; Pallandre, A.; De Lambert, B.; Houdayer, C.; Brugg, B.; Peyrin, J.-M.; et al. A “dry and wet Hybrid” lithography technique for multilevel replication templates: Applications to microfluidic neuron culture and two-phase global mixing. Biomicrofluidics 2011, 5, 024102. [Google Scholar] [CrossRef] [PubMed]
- Zyman, Z.; Cao, Y.; Zhang, X. Periodic crystallization effect in the surface layers of coatings during plasma spraying of hydroxyapatite. Biomaterials 1993, 14, 1140–1144. [Google Scholar] [CrossRef] [PubMed]
- Cavallini, M. Inhomogeneous thin deposits: A strategy to exploit their functionality. J. Mater. Chem. 2009, 19, 6085–6092. [Google Scholar] [CrossRef]
- Gentili, D.; Valle, F.; Albonetti, C.; Liscio, F.; Cavallini, M. Self-organization of functional materials in confinement. Acc. Chem. Res. 2014, 47, 2692–2699. [Google Scholar] [CrossRef]
- Gentili, D.; Gazzano, M.; Melucci, M.; Jones, D.; Cavallini, M. Polymorphism as an additional functionality of materials for technological applications at surfaces and interfaces. Chem. Soc. Rev. 2019, 48, 2502–2517. [Google Scholar] [CrossRef]
- Di Silvio, L.; Lunedei, E.; Gentili, D.; Barbalinardo, M.; Manet, I.; Milita, S.; Liscio, F.; Fraleoni-Morgera, A.; Cavallini, M. Combined wet lithography and fractional precipitation as a tool for fabrication of spatially controlled nanostructures of poly(3-Hexylthiophene) ordered aggregates. Nanoscale 2020, 12, 1432–1437. [Google Scholar] [CrossRef]
- Gentili, D.; Sonar, P.; Liscio, F.; Cramer, T.; Ferlauto, L.; Leonardi, F.; Milita, S.; Dodabalapur, A.; Cavallini, M. Logic-gate devices based on printed polymer semiconducting nanostripes. Nano Lett. 2013, 13, 3643–3647. [Google Scholar] [CrossRef] [PubMed]
- Kovacs, T.; Szucs, R.; Hollo, G.; Zuba, Z.; Molnar, J.; Christenson, H.K.; Lagzi, I. Self-assembly of chiral menthol molecules from a liquid film into ring-banded spherulites. Cryst. Growth Des. 2019, 19, 4063–4069. [Google Scholar] [CrossRef]
- Cahn, J.W.; Hilliard, J.E. Free energy of a nonuniform system. I. Interfacial free energy. J. Chem. Phys. 1958, 28, 258–267. [Google Scholar] [CrossRef]
- Antal, T.; Droz, M.; Magnin, J.; Rácz, Z. Formation of Liesegang patterns: A spinodal decomposition scenario. Phys. Rev. Lett. 1999, 83, 2880–2883. [Google Scholar] [CrossRef]
- Rácz, Z. Formation of Liesegang Patterns. Physica A 1999, 274, 50–59. [Google Scholar] [CrossRef]
- Thomas, S.; Lagzi, I.; Molnár, F.; Rácz, Z. Probability of the emergence of helical precipitation patterns in the wake of reaction-diffusion fronts. Phys. Rev. Lett. 2013, 110, 78303. [Google Scholar] [CrossRef] [PubMed]
- Carvalho, D.; Müller, S.C.; Rahne, T.; Tsuji, K.; Polezhaev, A. Zig-zag structures in silver dichromate precipitate. Chaos 2023, 33, 083148. [Google Scholar] [CrossRef]
- Deegan, R.D.; Bakajin, O.; Dupont, T.F.; Huber, G.; Nagel, S.R.; Witten, T.A. Capillary flow as the cause of ring stains from dried liquid drops. Nature 1997, 389, 827–829. [Google Scholar] [CrossRef]
- Yang, M.; Chen, D.; Hu, J.; Zheng, X.; Lin, Z.-J.; Zhu, H. The Application of coffee-ring effect in analytical chemistry. TrAC Trend Anal. Chem. 2022, 157, 116752. [Google Scholar] [CrossRef]
- Iwamoto, K.; Mitomo, S.I.; Seno, M. Rhythmic crystallization of ascorbic acid precipitated from its methanol solutions. J. Colloid Interface Sci. 1984, 102, 477–482. [Google Scholar] [CrossRef]
- Shipenok, X.M.; Mazhikenova, A.M.; Glukhovskoy, E.G.; Shipovskaya, A.B. Phase separation of l-menthol an aqueous dispersion of biologically active nanoparticles of chitosan l- and d-aspartate. J. Biomed. Photonics Eng. 2024, in press. [Google Scholar] [CrossRef]
Disclaimer/Publisher’s Note: The statements, opinions and data contained in all publications are solely those of the individual author(s) and contributor(s) and not of MDPI and/or the editor(s). MDPI and/or the editor(s) disclaim responsibility for any injury to people or property resulting from any ideas, methods, instructions or products referred to in the content. |
© 2024 by the authors. Licensee MDPI, Basel, Switzerland. This article is an open access article distributed under the terms and conditions of the Creative Commons Attribution (CC BY) license (https://creativecommons.org/licenses/by/4.0/).